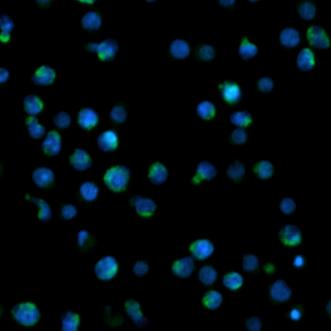

抗体相互作用、CD-marker分析、细胞增殖、细胞凋亡、细胞周期研究等等
Synentec全视野细胞扫描分析仪
产品简介
德国SYNENTEC GmbH成立于2005,由两名工程师Stefan Hummel and Matthias Pirsch创立,10多年来于全自动细胞成像系统的研发。CELLAVISTA和NYONE,兼具全自动、高通量、高速、高质量、多通道等特点,应用于生物药研发、生产等领域。
单克隆抗体药物的细胞株开发领域有⼀个普遍期望,即证明主细胞库(MCB)来源于单个细胞,以保证所生产出药物的质量。成像提供了⼀种可视化的数据支持,来确保生产细胞系的克隆起源。
CELLAVISTA和NYONE细胞成像系统可提供每个孔板的高分辨率的图像,记录接种day 0时的单一细胞证据,并且监测后续过程的细胞增殖情况;同时提供符合管理部门审计要求的报告形式,单克隆源性符合中美双报法规要求。应用领域:
l单克隆监测(SCC,FSCC)、单克隆源性证明图片、细胞计数(台盼蓝计数、荧光计数),可以96孔板计数
l转染效率、CRISPR/Cas基因编辑
lIgG Titer测定/糖基化监测(使⽤PAIA试剂盒)
l抗体相互作用、CD-marker分析、细胞增殖、细胞凋亡、细胞周期研究等等
细胞增殖 | 细胞周期和有丝分裂 | CD Marker | 循环肿瘤细胞研究 |
|
| |
|
氧化应激 | 微球定量 | 病毒滴度 | 病毒感染研究 |
|
|
|
|
细胞凋亡 | 细胞活率 | 转染效率 | 线粒体膜电位 |
|
| |
|
细胞凋亡研究 | 伤口愈合实验 | 抗体研究 | DNA-Damage 检测 |
|
| |
|
CELLAVISTA和NYONE还提供FASCC(荧光单克隆成像),明场成像的缺点,利用短期、无毒、无动物源性的染料进行全自动筛选,可快速准确的获得单克隆证据。
高质量细胞图像,孔边缘高清成像、高速、高精度、自动对焦、自动图像拼接
多种孔板类型(6、12、24、96、384)、多种荧光通路选择
符合21CFRpart11的软件、快速准确识别单细胞、避免边缘效应
精准排除紧邻或重叠细胞
单独复拍,完全避免拼接的影响,单克隆性准确率大于99%
软件自动追踪单克隆生长过程,生成连续的克隆图谱
孔边缘高清成像,自动对焦,无缝拼接,10倍镜下整板扫描时间6-7minutes
96孔整孔扫描(3min) 20μl样本体积 自动批量图片及数据分析 结果可以经典方法比对
| |
10×倍物镜拍摄 聚团分析 高通量, 低样本体积 | |
细胞边缘尖锐,死活细胞能正确区分 | |
如果细胞在孔内不是均匀分布,产生堆积,这样也会影响结果,所以加样的时候尽量吹打混匀一下 | |
平行转染GFP 监控荧光细胞百分比 贴壁细胞和悬浮细胞适应性细胞、合流( 1F ) 悬浮细胞计数( 1F ) | |
参数
型号 | CELLAVISTA | ||
Basic | Highend | ||
光源 | 白光(LED | √ | √ |
max. | - | √ | |
max. | - | - | |
物镜 | 2×(NA | Opt. | Opt. |
4×(NA | √ | √ | |
10×(NA | √ | √ | |
20×(NA | Opt. | Opt. | |
40×(NA | Opt. | Opt. | |
可升级性 | √ | - | |
测量方法 | 数码成像 | ||
板型 | (SBS | ||
相机 | 类型 | Progressive | |
像素密度 | 5440×5440 | 4496×4496 | |
图像分辨率 | 29.6 | 20.2 MP | |
像素尺⼨ | 3.2 | 2.74×2.74 µm | |
Digital | 8 | ||
刷新频率 | 15fps | 18fps | |
测量时间 | 96-well, | 2minutes | 4minutes |
384-well, | 3minutes | 6.5minutes | |
工作温度 | 20°C | ||
工作湿度 | 50 | ||
仪器尺寸 | 407/625/530 | 350/310/620(mm) | |
仪器重量 | 61kg | 35kg | |
电源选项 | 100 | ||
- 购买人 会员级别 数量 属性 购买时间
- 商品满意度 :
-